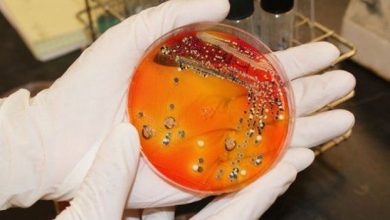

holeră
-
Turism

Risc pentru cei care merg la mare în Turcia / Bacterii periculoase / Ce e de făcut
Risc pentru cei care merg la mare în Turcia. Bacteriile Vibrio s-au răspândit îngrijorător, iar experții au tras un semnal…
Citește mai mult » -
Sănătate

Caz de holeră într-o țară vecină cu România / Destinație favorită pentru vacanțe
Caz de holeră într-o țară vecină cu România. S-a înregistrat primul caz de holeră în Bulgaria, după 103 ani! Pacientul…
Citește mai mult » -
Turism

Bulgaria rămâne destinația favorită de vacanță a românilor / Despre temerile cu holera…
Bulgaria rămâne destinația favorită de vacanță a românilor Zvonurile conform cărora apa Mării Negre ar putea fi contaminată cu diferite…
Citește mai mult » -
Sănătate

O BOALĂ NECUNOSCUTĂ a pus pe jar OMS!
O maladie misterioasă este la originea deceselor a cel puțin 100 de persoane în Sudanul de Sud. Organizația Mondială...
Citește mai mult » -
Expres

Epidemie de HOLERĂ!!!
Autoritățile din Sanaa (capitala Yemenului) au declarat în noaptea de duminică spre luni stare de urgență, din cauza creșterii...
Citește mai mult » -
112

Cazuri de HOLERĂ în Yemen!!!
Potrivit Organizației Mondiale a Sănătății (OMS) au fost confirmate 51 de cazuri de holeră în Yemen, alte 1.180 fiind...
Citește mai mult » -
Expres

UPDATE. Uraganul Matthew aduce și holeră
Uraganul Matthew a ucis 900 de oameni in Haiti, iar acum și holera face primele victime. În același timp, în…
Citește mai mult » -
Expres
Atenţionare MAE! Este epidemie de HOLERĂ
Ministerul Afacerilor Externe a emis astăzi o atenţionare de călătorie prin care informează cetăţenii români care se deplasează...
Citește mai mult » -
Expres

Foamete! Oamenii mănâncă pietre!
Din cauza faptului că toate culturile agricole sunt distruse, apa potabilă este contaminată şi alimentele s-au terminat,...
Citește mai mult »
